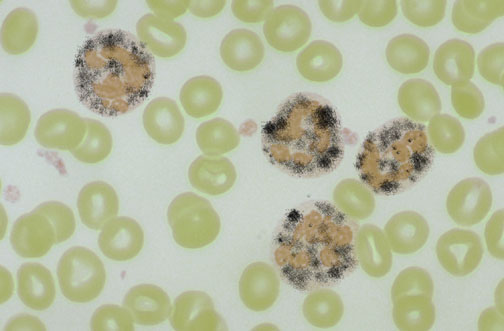

| The nitroblue tetrazolium (NBT) slide test is used for screening defects in NADPH oxidase. In this test, patient neutrophils are exposed to a stimulus, incubated with NBT, and made into a smear on a slide. Under the microscope, the number of neutrophils with dark granules of reaction product are counted. Normally, more than 95% of the granulocytes will be positive as shown above. In chronic granulomatous disease (CGD) there is an absent or reduced function of the respiratory burst, which is the intracellular process in neutrophils that is dependent upon the enzyme NADPH oxidase, which produces oxygen free radicals used to kill phagocytized organisms. The abnormal NBT test in CGD is shown below in which <5% of neutrophils stain. |
![]() |